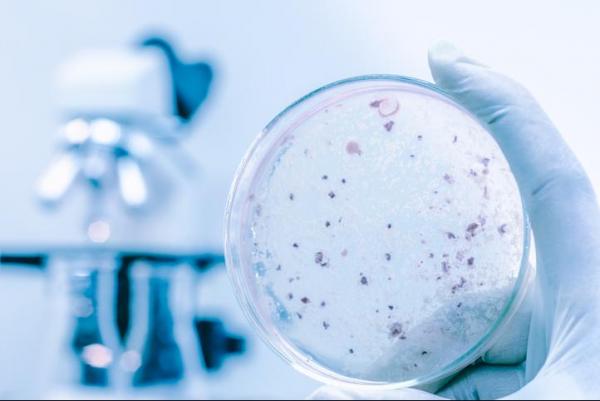

MÁSTER EXPERTO EN LEGIONELOSIS, SALUD Y PREVENCIÓN
-
Recibí la titulación y el certificado de profesionalidad dentro del plazo. Fue online pero si tenía alguna duda estaba bien atendido por el profesorado. Bastante satisfecho en general. Aprendí bastante. Lo recomiendo.
← | →
Master
Online

¿Necesitas un coach de formación?
Te ayudará a comparar y elegir el mejor curso para ti y a financiar tu matrícula en cómodos plazos.
Descripción
-
Tipología
Master
-
Metodología
Online
-
Horas lectivas
300h
-
Duración
1 Año
-
Inicio
Fechas a elegir
Lánzate a una carrera profesional centrada en la salud con el Máster Experto en Legionelosis, Salud y Prevención impartido Esneca Business School en modalidad online, disponible a través de Emagister. Este programa te brindará las herramientas esenciales para aumentar tus oportunidades laborales en el campo de la seguridad alimentaria y la prevención de enfermedades, como la legionelosis, dentro de la industria de la salud pública.
En este máster, tienes la oportunidad de explorar a fondo los aspectos críticos de la seguridad alimentaria, enfocándote en las enfermedades transmitidas por el mal manejo o tratamiento de alimentos, como es el caso de la legionelosis. Aprendes sobre los criterios generales de limpieza y desinfección, la importancia de la salud pública y la higiene laboral, así como el marco normativo que rige estas prácticas, ofreciéndote una comprensión integral y detallada de todos los conceptos relacionados con la seguridad alimentaria. En particular, profundizas en los fundamentos de la seguridad alimentaria y la importancia sanitaria de la legionelosis. Descubres cómo identificar, prevenir y controlar esta enfermedad, así como su relevancia en el contexto de la salud pública y la prevención de riesgos sanitarios.
No esperes más, para obtener información adicional de este curso, haz clic en el botón "Pide información" que encontrarás en esta página de Emagister. Completa los datos solicitados y pronto un asesor se comunicará contigo para proporcionarte todos los detalles que necesites.
Información importante
Precio a usuarios Emagister:
Instalaciones y fechas
Ubicación
Inicio
Inicio
A tener en cuenta
Permite conocer los aspectos de la seguridad alimentaria, haciendo hincapié en enfermedades que se transmiten a través del mal uso o tratamiento de los alimentos, como es el caso de la legionelosis, entre otras.
El Máster Experto en Legionelosis, Salud y Prevención está destinado a todas aquellas personas que pretendan adquirir todos los conocimientos necesarios en este ámbito profesional y poder desarrollarlos de forma eficiente en el mundo laboral.
No es necesario cumplir con requisitos previos para realizar esta formación.
Una vez finalizados los estudios y superadas las pruebas de evaluación, el alumno recibirá un diploma que certifica el “MÁSTER EXPERTO EN LEGIONELOSIS, SALUD Y PREVENCIÓN”, de ESNECA BUSINESS SCHOOL, avalada por nuestra condición de socios de la CECAP, AEC y AEEN, máximas instituciones españolas en formación y de calidad. Los diplomas, además, llevan el sello de Notario Europeo, que da fe de la validez, contenidos y autenticidad del título a nivel nacional e internacional.
Grupo Esneca Formación te ofrece un nuevo servicio de bolsa de empleo y estancias formativas. El alumno encontrará más de 10.000 ofertas de estancias formativas y empleo tanto a nivel nacional como internacional a su disposición. La bolsa de empleo ayuda a estudiantes y recién titulados a encontrar primeros empleos y estancias formativas a nivel nacional y en el extranjero, sobretodo en Europa.
Inspector sanitario. Coordinador de seguridad alimentaria. Consultor en prevención de Legionelosis. Responsable de higiene y salud pública.
Puedes elegir entre métodos de pago como PayPal, disponible para todos los países. Si prefieres usar tu tarjeta de crédito (Visa, Master Card, Discover o American Express). Además, ofrecen la opción de pago fraccionado a través de la financiera APLAZAME.
Ejemplo de financiación con APLAZAME para una cesta de 380,00 € a 11 meses y que comienza a pagar a los 30 días desde la solicitud. Se solicita una entrada de 33,90 € que el usuario debe pagar a través de su tarjeta en el momento en que realiza la operación. El importe a financiar es la diferencia entre el valor de la cesta y la entrada: 346,10 €. Se solicitan 11 mensualidades de 33,90 €. Comisión de apertura: 0,00 €. TIN: 16,62% TAE: 17,95%. Importe total adeudado: 406,82 €. Por el momento el curso no dispone de becas, pero si quieres una información más detallada comunícate con un asesor.
Para registrarte en el curso, simplemente haz clic en el botón "Pide información". Posteriormente, completa el formulario de contacto, y uno de nuestros asesores se comunicará contigo para brindarte orientación en el proceso de matriculación.
Opiniones
-
Recibí la titulación y el certificado de profesionalidad dentro del plazo. Fue online pero si tenía alguna duda estaba bien atendido por el profesorado. Bastante satisfecho en general. Aprendí bastante. Lo recomiendo.
← | →
Valoración del curso
Lo recomiendan
Valoración del Centro
José Miguel Zurita Beltran
Logros de este Centro
Todos los cursos están actualizados
La valoración media es superior a 3,7
Más de 50 opiniones en los últimos 12 meses
Este centro lleva 12 años en Emagister.
Materias
- Seguridad alimentaria
- Medidas preventivas
- Vigilancia epidemiológica
- Marco normativo
- Limpieza y desinfección
- Toma de muestras
- Marco normativo específico de la legionela
- Riesgos derivados del uso de productos químicos
- Riesgos sobre la salud
- Salud pública y salud laboral
- Importancia sanitaria de la legionelosis
- Instalaciones de riesgo
- Biología y ecología del agente causal
- Cadena epidemiológica de la enfermedad
- Sistemas de vigilancia epidemiológica
- Control analítico
- Información sobre los riesgos
- Programa de mantenimiento o tratamiento
- Toma de muestras y medición in situ
Temario
LEGISLACIÓN SANITARIA Y LEGIONELOSIS
UNIDAD DIDÁCTICA 1. FUNDAMENTO DE AL SEGURIDAD ALIMENTARIA
1. Introducción
2. ¿Qué se entiende por seguridad alimentaria?
3. La cadena alimentaria: "del campo a la mesa"
4. ¿Qué se entiende por trazabilidad?
UNIDAD DIDÁCTICA 2. IMPORTANCIA SANITARIA DE LA LEGIONELOSIS
1. Introducción
2. Biología y ecología del agente causal
3. Cadena epidemiológica de la enfermedad
4. Sistemas de vigilancia epidemiológica
5. Instalaciones de riesgo
UNIDAD DIDÁCTICA 3. MARCO NORMATIVO ESPECÍFICO DE LA
LEGIONELA
1. Legislación vigente en materia de prevención y control de legionelosis
2. Anexos: marco normativo específico de la Legionela.
UNIDAD DIDÁCTICA 4. INSTALACIONES DE RIESGO EN EL ÁMBITO DE
APLICACIÓN
1. Diseño, funcionamiento y modelos
2. Programa de mantenimiento o tratamiento
3. Toma de muestras
4. Control analítico
UNIDAD DIDÁCTICA 5. CRITERIOS GENERALES DE LIMPIEZA Y
DESINFECCIÓN
1. Conocimientos generales de la química del agua
2. Buenas prácticas de limpieza y desinfección
3. Tipos de productos: desinfectantes, antiincrustantes, anticorrosivos,
biodispersantes o neutralizantes
4. Registro de productos autorizados
5. Otros tipos de desinfección. Métodos físicos y físico-químicos
UNIDAD DIDÁCTICA 6. SALUD PÚBLICA Y SALUD LABORAL.
SEGURIDAD E HIGIENE LABORAL
1. Conceptos
2. Marco normativo
3. Riesgos derivados del uso de productos químicos. Riesgos sobre la salud
4. Medidas preventivas
5. Información sobre los riesgos
UNIDAD DIDÁCTICA 7. PRÁCTICAS
1. Introducción
2. Visitas a instalaciones
3. Toma de muestras y medición in situ
4. Interpretación de la etiqueta de productos químicos
5. Preparación de disoluciones de productos a distintas concentraciones
6. Cumplimiento de la hoja de registros de mantenimiento
7. Anexos
Información adicional
*El contenido del curso se encuentra orientado hacia la adquisición de formación teórica complementaria. Este curso no conduce a la obtención de una titulación oficial.
¿Necesitas un coach de formación?
Te ayudará a comparar y elegir el mejor curso para ti y a financiar tu matrícula en cómodos plazos.
MÁSTER EXPERTO EN LEGIONELOSIS, SALUD Y PREVENCIÓN